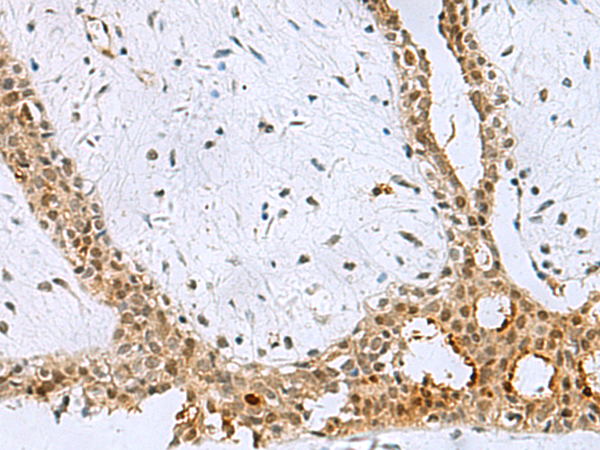

中文名稱:兔抗BCL7B多克隆抗體
|
Background: |
This gene encodes a member of the BCL7 family including BCL7A, BCL7B and BCL7C proteins. This member is BCL7B, which contains a region that is highly similar to the N-terminal segment of BCL7A or BCL7C proteins. The BCL7A protein is encoded by the gene known to be directly involved in a three-way gene translocation in a Burkitt lymphoma cell line. This gene is located at a chromosomal region commonly deleted in Williams syndrome. This gene is highly conserved from C. elegans to human. Multiple alternatively spliced transcript variants have been found for this gene. |
|
Applications: |
ELISA, IHC |
|
Name of antibody: |
BCL7B |
|
Immunogen: |
Fusion protein of human BCL7B |
|
Full name: |
BCL tumor suppressor 7B |
|
SwissProt: |
Q9BQE9 |
|
ELISA Recommended dilution: |
5000-10000 |
|
IHC positive control: |
Human ovarian cancer and Human thyroid cancer |
|
IHC Recommend dilution: |
50-200 |

購物車
購物車 幫助
幫助
 021-54845833/15800441009
021-54845833/15800441009
